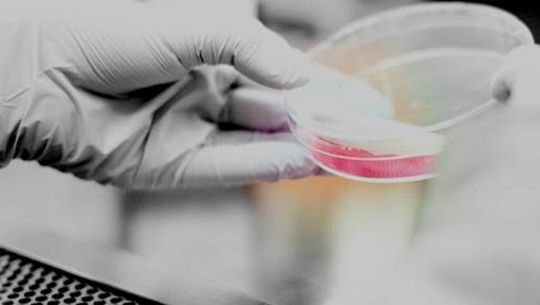

16 Nov En el futuro se podrían crear órganos para trasplantes a pedido y sin dilemas éticos
Científicos del Instituto Weizmann han hecho un avance significativo en el aprovechamiento de las células madre para crear órganos para trasplantes.
En una entrevista, el investigador principal, llegó al extremo de postular que el avance podría abrir las puertas a la regeneración de células humanas, creación de esperma, investigación en terapia génica, ingeniería genética y fusión de ADN.
Uno de los obstáculos del empleo de células madre embrionarias humanas para uso médico reside en su mera promesa: Nacen para diferenciarse rápidamente en otros tipos de células. Hasta ahora, los científicos no han sido capaces de conservar células madre embrionarias en su prístino estado madre.
La alternativa propuesta para las células madre embrionarias, células adultas reprogramadas llamadas células madre pluripotentes inducidas (células iPS), tiene limitaciones similares.
Si bien éstas se pueden diferenciar en muchos tipos de células distintas, retienen signos de “imprimación” (compromiso con linajes celulares específicos).
Un equipo del Instituto Científico Weizmann ha dado ahora un gran paso hacia la eliminación de dicho obstáculo.
Este equipo ha creado células iPS que están completamente “reiniciadas” al estado más temprano posible y las ha mantenido en ese estado.
Entre otras cosas, esta investigación puede, abrir el camino hacia la capacidad de generar órganos para trasplante a pedido.
Desde su creación en el año 2006, las células iPS se consideran como un sustituto ético y práctico para las células madre embrionarias.
Se generan insertando cuatro genes en los genomas de células adultas tales como las células cutáneas.
Esto da marcha atrás al reloj del desarrollo casi hasta el principio, pero no completamente, hasta llegar a un estado similar al de la célula madre embrionaria.
El Doctor Jacob Hanna del Departamento de Genética Molecular del Instituto y su equipo, incluyendo los estudiantes de investigación Ohad Gafni y Leehee Weinberger e investigadores del Centro Nacional de Israel de Medicina Personalizada, llegaron a la conclusión de que la inserción de genes para reiniciar las células madre no era suficiente.
También se debe poner en suspenso el impulso de diferenciación de las células.
Una pista de que esto podría ser posible fue el hecho de que las células madre embrionarias de ratones utilizadas en numerosos experimentos de laboratorio son fácilmente preservadas en su estado “ingenuo”, no imprimado, y no presentan algunos de los problemas que presentan las células humanas.
Hanna y su grupo se dieron cuenta de que si podían entender cómo las células madre embrionarias de ratones pueden evitar diferenciarse en el laboratorio, esto se podría aplicar a las versiones humanas.
Mediante experimentos de laboratorio y análisis genético, el equipo elaboró un “tratamiento” para las células iPS en la placa de Petri, para reducir la ruta genética de diferenciación.
Luego inyectaron las células iPS tratadas en blastocitos de ratón (embriones en etapa inicial que contienen unas pocas células).
Si las células iPS del equipo son realmente ingenuas y viables, pueden crecer junto con las células de ratón.
El agregado de un marcador fluorescente a las células iPS les permitió rastrear lo que ocurrió a las células madre en el embrión en desarrollo.
Las imágenes fluorescentes tomadas luego de diez días (los embriones no fueron llevados a término) revelaron de hecho que los embriones contenían tejido de ratón y tejido humano.
“Estas células corresponden a las etapas más tempranas de las células madre embrionarias humanas que han sido aisladas. Hemos logrado congelar lo que es esencialmente un estado sumamente breve; y producir un nuevo estado ingenuo y pluripotente en células madre.”
Estos hallazgos pueden tener muchos usos en el campo de la investigación biomédica, específicamente en la investigación de terapia genética y en ingeniería genética. Hanna y su equipo tienen la intención de seguir investigando los embriones de ratón “humanizados”, en los cuales esperan encontrar formas de dirigir el desarrollo del tejido humano en órganos funcionales.
Fuente: Latam Israel


